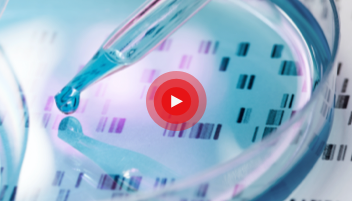

深刻见解与资源
制药服务行业继续教育资源
我们拥有多名行业专家,并且与整个制药和临床试验行业的科研技术专家合作,为您提供白皮书、文章和网络讲座等,帮助您完成分子药物开发的各个阶段。
使用菜单按钮缩小搜索范围,或使用下方的筛选器来按照类别、行业专家或内容类型搜索整个资料库。
在下载资料前,您可能会先受邀填写联系表。
如有问题请联系我们
请选择您感兴趣的分类

电子书
重塑全球价值:中国创新药出海制胜策略与实践
赛默飞联合医药魔方发布蓝皮书《重塑全球价值:中国创新药出海制胜策略与实践》。报告基于多维行业数据与标杆案例,聚焦地缘风险与监管壁垒等核心挑战,系统解构出海全景,深入还原成功出海的关键决策与策略逻辑,并从路径选择到模式演进提供可落地的破局思路,助力企业走出去、走得稳、走得远。

白皮书
重塑中国创新药“出海”格局:趋势、挑战与供应链路径
本白皮书基于2015–2024 年中国创新药对外授权交易数据、全球化布局实践及典型合作案例,系统分析中国创新药出海的趋势、挑战与供应链路径选择,重点阐述如何通过CDMO 合作伙伴的CMC 技术平台、全球注册支持与加速开发框架,帮助企业突破从IND 到BLA的技术与监管瓶颈,为中国生物医药企业制定全球化开发策略提供参考。

电子书
2025年生物技术行业深度洞察:生物技术行业领导者如何应对行业挑战
赛默飞首次与领先的市场研究公司 Savanta 合作,对全球 152 位生物技术行业高层领导者进行了调研。基于高层领导者们的反馈,本报告深入剖析了行业领先的药企如何应对并攻克各类难题。

线上讲座
破浪出海: 中国生物药全球化征程后期中的CMC策略与风险破解
中国生物医药行业正迎来从“本土创新”到“全球出海”的关键跃升,越来越多的生物药企将目光投向国际市场,寻求更广阔的发展空间。在此过程中,CMC工作的复杂性和重要性被提升到前所未有的高度。本次线上讲座通过分享前沿洞察与实践经验,为企业提供应对策略与解决方案的深度思考。

“全心”科学博客
初创生物技术企业:错误的外包策略所付出的代价不仅是时间
对于处于早期阶段的生物技术公司而言,外包决策可能会成就或破坏项目推进的势头。一个战略上协调一致的发展模型,将前期规划与后续执行相连接,对避免延误、降低风险以及构建长期价值至关重要。
10分钟阅读时间

线上讲座
法规为基,韧性为翼:构建新常态下的临床供应链
面对复杂法规、物流与温控要求,构建合规且具韧性的临床供应链体系愈发重要。为此,赛默飞Patheon™ 特邀DIA中国监督科学专业委员会副主任委员刘艳玮女士与赛默飞临床供应链物流负责人吴雨甑女士,共同探讨临床供应链关键议题。

案例分享
构建韧性临床供应链:中国创新如何提升临床试验速度
在生物医药创新加速的今天,临床试验供应链已从辅助支持升级为核心竞争力要素。面对法规要求、复杂的物流条件以及严苛的温控要求,构建新常态下的临床供应链重要性不言而喻。在这样复杂的环境下,构建兼具合规性和韧性的临床供应链体系,已成为医药行业不可或缺的核心能力。

线上讲座
中国医药创新全球化的关键跃迁
本次线上讲座探讨中国医药创新在全球舞台上的定位。赛默飞临床供应链服务中国区质量负责人施维维将与多位行业专家一起深入分析从本土领先到世界级跃升的进程中,中国医药行业还面临哪些挑战和差距。

视频
微剂量给药技术概述
赛默飞凭借其创新的原料药胶囊填充技术,推动了临床试验药物生产的变革。这是一种先进的非预制剂解决方案,可将原料药 (API) 直接装入胶囊中,省去了传统的制剂生产步骤。这项前沿的微剂量给药技术能最大限度地减少浪费、降低分析工作量、缩短药物开发周期,同时还能保护珍贵的原料药 (API),这对早期临床试验而言至关重要。

博客
生物药细胞株开发技术:提升稳定性和产量
细胞株开发对于生物制药至关重要,它影响着效率、可扩展性和产品稳定性。CHO-K1细胞株工程的进步正在推动更高的产量、改善的基因稳定性和更快的IND申请路径。
15分钟阅读时间

电子书
依托创新 360° CDMO 与 CRO 解决方案, 加速药物开发:助力简化药物开发流程并缩短药物上市时间的综合指南
本电子书详细阐述了如何在药物开发的各个阶段最大程度地利用各种资源并尽可能降低风险,帮助所有的药物申办者推进其独特的药物开发进程,更快实现将药物交付给患者的目标。

Expert

线上讲座
创新药航海图:资产跨境合作全维度
本次讲座将围绕肿瘤领域合作热点、国际环境对创新药开发与合作影响、供应链安全及支付策略等话题展开,探讨中国药企如何在国际竞争合作中构建安全、高效且高价值的全球化发展路径。

口服固体制剂 (OSD) 处方开发早期阶段的五大隐藏风险
早期阶段的固体口服剂型开发存在一系列隐性风险,这些风险可能影响长期成功。从活性药物成分的复杂性到可扩展性和监管准备,周密的规划可以帮助减轻挫折并保持项目进展。
阅读时间:12分钟

生物药临床试验价值驱动:包装与贴标的战略性影响
有效的临床包装和标签通过确保合规性、保护产品完整性和提升试验效率来创造价值。采取战略性方法有助于生物技术申办方降低风险、适应试验需求,并优化成本、速度和可靠性。
阅读时长:15分钟

线上讲座
保障样本安全:关键生物材料的保护策略
在近期的线上讲座中,我们探讨了如何借助合适的CDMO合作伙伴优化生物材料存储流程、降低风险,并提供从临床试验到商业上市所需的可扩展性支持,从而助力药企推进研发管线。

通过一体化团队协作模式优化临床供应管理
下载案例分享,了解我们的 CDMO 和 CRO 服务如何帮助 NewAmsterdam Pharma 为 835 个临床站点的 12,000 多名患者提供临床试验用药。

解锁欧洲市场准入:本地化口服固体制剂(OSF)生产的竞争优势
在瞬息万变的制药行业中,对于致力于开拓欧洲广阔市场的制药企业而言,在欧洲构建本地化生产布局已成为一项关键战略。除了能够触及高价值市场外,在欧洲设立本地化工厂还带来了诸多优势,包括深厚的监管专业知识积累以及稳定性更高的供应链体系。
阅读时间:15分钟

博客
冷链物流的关键作用:从实验室到患者手中,全程守护药品完整性
本博客探讨了冷链物流在生物制药行业中的关键作用,并解释了 CDMO/CRO 合作伙伴如何帮助药物开发商保护其产品的完整性。
阅读时间:12分钟

专家
Paul Jorjorian
Vice President and General Manager, Biologics
Scientific Expertise:
- Research and development
- Process and analytical development
- MSAT strategy
- Biologics manufacturing
- Technology transfer
专注的领域
生物制品(大分子原料药)
Credentials
Bachelor’s degree in chemical engineering and management, Purdue University
Master’s in chemical engineering, Cornell University

资料页
Quick to Clinic™平台加速生物制剂开发进程
面对尽早提交 IND 的压力,申办方往往会将加速 I 期安全性测试列为优先事项。通过 Quick to Clinic™ 计划,赛默飞可以帮助您在转染开始后的短短 13 个月内将大分子原料药交付用于 首次人体试验研究。

博客
预灌封注射器:容易忽视的三大痛点
随着制药公司越来越以患者为中心,某些制剂在践行这一理念方面走在了最前列。就无菌注射制剂而言,预灌封注射器能够为患者和临床医生带来更多的便利,并由于诸多其它原因而逐渐受到患者的欢迎。预灌封注射器是患者和临床医生的福音...
阅读时间:5分钟

博客
mRNA 治疗药物的发展趋势:新冠疫情期间积累的经验教训为 mRNA 治疗药物的成功奠定了基础
辉瑞-BioNTech 和莫德纳 (Moderna) 开发的信使 RNA (mRNA) 新冠疫苗快速从实验室研发阶段推进临床试验阶段,只用了不到一年的时间,这很好地证实了 mRNA 平台的应用前景,并且引发了将 mRNA 技术用于众多适应症的关注。1 赛默飞拥
阅读时间:5分钟

博客
疫苗的包装从西林瓶转变为预灌封注射器:三个关键成功因素
随着制药公司更加充分地践行“以患者为中心”的理念,加之患者可自我注射的制剂不断增多,预灌封注射器剂型市场规模预计也将随之扩张,到 2026 年将达到 95.3 亿美元。1 推动这一增长的主要因素是生物制剂的发展(图 1)...
阅读时间:4分钟

博客
选择合适的 CDMO,实现 mRNA 的成功:CDMO 必备的五大特征
在新冠疫情肆虐全球期间,mRNA 技术的应用前景已经得到了充分的证实,新冠疫苗以前所未有的速度上市使用。医药合同定制研发生产企业 (CDMO) 在新冠疫情期间发挥的重要作用将对其与制药公司间的关系产生持久的影响。CDMO 如果拥...
阅读时间:7分钟

博客
战胜新冠疫情的一线希望:加快疫苗开发
疫苗开发过程漫长,费用高昂,损耗率高,而且为了让人人都能接种到获得许可的疫苗,候选疫苗需要多次迭代。大流行病和流行病疫苗的开发是有风险的,由于病毒的新颖性,某些未知因素会干扰疫苗项目。例如寨卡疫情——在疫苗完全开发之...
阅读时间:6分钟

博客
与临床辅材有关的误区和真相
人们往往以为临床辅材不如临床试验用药物重要。临床试验申办者经常会把注意力集中在药物上,而忽视了设备、仪器和耗材等其他必需用品,这些用品统称为临床辅材...
阅读时间:2分钟

线上讲座
在药品开发过程中实现价值最大化:采用新的 CDMO 和 CRO 合作方式
了解将 CDMO 和 CRO 服务和解决方案集成到一个综合模型下如何提高效率、缩短时间并帮助更快地向患者提供高质量的疗法。

博客
细胞疗法的新兴趋势:自体和同种异体细胞疗法的发展前景
在生物技术创新和研发投资增加的推动下,细胞治疗行业正在经历显着增长。尽管这些疗法前景广阔,但自体和同种异体治疗的复杂制造工艺也带来了重大挑战。作为生产合作伙伴,赛默飞的承诺是始终处于这些进步的前沿,推动创新并确保细胞疗法开发和制造达到高标准。
阅读本文需要 10 分钟
文章
文章

博客
欧洲监管形势:关于符合英国脱欧后质量授权人要求的重要建议
除了新冠疫情造成的影响,英国脱欧为欧洲临床试验供应链又增加一重复杂性。自 2021 年 1 月起,欧盟和英国的法律管辖权和监管管辖权不再相同,药品必须满足目标市场的相关要求...
阅读时间:4分钟

白皮书
技术转移:提高成功几率并管控风险的优秀实践
药品从开发到商业化上市需要高协调性的技术转移过程,这涉及到多个利益相关方,需要各方深入了解不同项目具体的决定因素,同时还需要构建一个完善的框架来持续评估商业活动、监管合规、药物质量和技术风险。

博客
技术转移系列博客二:战略合作在药品技术转移中的重要性
战略伙伴关系有助于识别和减轻工艺风险,从而在成功的技术转让中发挥着至关重要的作用。优秀的战略合作伙伴可以帮助申办方确保项目时间表,克服常见的技术转让挑战,并节省大量成本。
阅读本文需要 10 分钟

博客
技术转移系列博客一:技术转移在药品生产中的关键作用
在制药生产中,高效的技术转让有助于保持产品质量、保护知识产权、管理成本和扩大运营规模,从而确保公司能够有效应对新的机遇或挑战,保持竞争优势,并确保不间断地向患者供应药品。
阅读时间:15分钟

博客
冻干工艺热点问题解答
冻干是制药过程中无菌制剂灌装阶段的一项关键工艺,尤其适用于稳定性要求高且需要延长有效期的药品。冻干工艺是指在低温和真空条件下除去冷冻制剂中的水分,同时不影响制剂的结构完整性和有效性。在不影响制剂结构完整性的情况下将制剂变为干粉对于保持生物制品(如疫苗、抗体和其他蛋白类药物)的稳定性和有效性尤为重要。
阅读时长:15分钟
文章

线上讲座
从本地到全球:MRCT中对照药采购策略和法律洞察
随着新药开发趋于全球化,国际多中心临床试验已经被广泛应用。本线上讲座将重点关注MRCT中的对照药采购策略和法律洞察,帮助申办方提前筹划MRCT项目。

线上讲座
创新药“出海”导航:多地区临床试验的趋势与质量策略
出海面临的挑战花样繁多,而多国家多中心临床试验比一般的临床试验更为复杂。欢迎观看线上讲座,深入了解如何更好布局创新药出海背景下的临床试验。

白皮书
对照药短缺危机:抗肿瘤药对照药采购的主要挑战及应对策略
选择合适的对照药对于评估新治疗的安全性和有效性至关重要。本文将阐述在抗肿瘤药临床试验中对照药采购所面临的的主要挑战,并提出潜在的解决方案。
文章

资料页
由行业专家支持的全球监管合规服务
熟悉复杂的监管合规环境对于成功实现粉子药品生命周期的管理很重要。赛默飞提供一系列灵活的监管合规解决方案,可以帮助您轻松应对分子药品的独特需求和挑战,同时我们的全球网络和经验丰富的监管合规领域专家还能为您提供支持服务。

欧洲监管形势:解读欧盟和英国药品供应质量授权人(QP)新规
为确保完全合规和及时高效的批次放行流程,在欧盟和英国进行临床试验和商业化的药品申办者需要深入了解欧洲 GMP 要求以及欧盟和英国 QP 在新监管环境下的职责。本白皮书就此主题提供了重要的指导和支持。

线上讲座
应对欧盟的监管形势:加快药品开发、疗法创新和上市速度
为了应对日新月异的科技进步,欧盟正在大刀阔斧地改革其法律架构。本系列线上讲座由三部分组成,介绍为了成功完成注册申报,申办方在药品开发过程中必须注意的关键事项。

博客
CRDMO 的崛起:CRO/CDMO 整合重塑药品开发
如今的药品申办方在通常情况下都会选择与 CRO、CMO 和 CDMO 合作,以帮助满足其研究、开发和生产需求。在本博客中,我们将探讨选择与一体化 CRO/CDMO 合作的五大优势。
阅读时长:9分钟

博客
探索药品开发的五个阶段
一款新药想要“成功上市销售”,就必须经历五个特定的阶段:1) 发现和开发阶段,2) 临床前研究阶段,3) 临床试验阶段,4) FDA 评审阶段,以及 5) 药品属性监测阶段
阅读时长:9分钟

线上讲座
应对mRNA产品商业化过程中的行业挑战
新冠肺炎疫情期间,mRNA 疫苗的快速开发和审批重新点燃了人们对mRNA 技术的新兴趣。科学家们正在探索 mRNA 技术的新应用领域,如针对肿艾滋病毒、罕见病,以及用于个性化医疗。虽然 mRNA 的生产速度快,且应用灵活,但要充分发挥其潜力并进一步扩大其应用范围,我们还必须应对众多的行业挑战。了解更多信息。

线上讲座
基因疗法产品开发和生产综合方法的优势
赛默飞的专家将带您了解用于基因疗法产品的病毒载体从开发到上市使用的全过程,帮助您克服挑战,及时交付药品、减少成本。采用基因疗法产品开发和生产的集成方法,您不仅仅可以定制解决方案,还可以改善协作、简化决策、更加有效地利用资源。

线上讲座
通过一体化CRO/CDMO合作伙伴关系改善患者的细胞治疗体验
观看此线上讲座,您可以深入了解与单个一体化 CRO/CDMO 伙伴合作如何从容应对行业挑战,如何快速完成基因疗法产品从开发到生产,以及团结协作的团队和完善的基础设施所具备的优势。

线上讲座
应对在中国境内外采购对照药物面临的挑战和主要考虑因素
对照药采购对于临床试验的成功与否很重要,但不可否认的是采购过程很复杂,在海外进行对照药采购时尤为如此。了解如何应对在中国境内外采购对照药时面临的挑战。
文章

白皮书
CDMO战略合作伙伴:利用基础设施投资和创新加快生物药开发
要在颠覆性变革时期应对生物药开发的挑战,就必须了解推动变革的科技和市场力量,并采取相应的策略。对于大多数药企和生物技术企业而言,这意味着要找到可靠的CDMO,他们要具备创新的技术和方法、满足持续增长生物药需求的充足产能、深厚的监管合规只是,以及加快上市速度所需的操作效率。本白皮书介绍了如何评估和选择合适的CDMO,以便向患者快速提供前景广阔的生物药。

信息图
加快IND/IMPD申报的五大方法
IND/IMPD申报之路并非一帆风顺,在速度、风险和未来需求之间取得平衡是一项挑战。如何在不牺牲质量和未来商业化目标的情况下加快IND/IMPD申报?赛默飞专家就加快和优化早期开发过程提出了若干建议。

博客
使用电子标签的时代已经到来
新欧盟临床试验法规 (CTR) 旨在简化临床试验管理,为欧洲的制药公司创造更舒适的经营环境。该法规统一了监管、贴标和质量授权人 (QP) 要求,具有法律约束力,申办者需要充分了解其要求。请继续阅读,了解该法规对制药行业的影响(包...
阅读时间:5分钟

白皮书

手册
中国临床试验对照药采购服务介绍
中国临床试验的高速发展带来了巨大的对照药采购需求,对照药物同时也是决定临床试验药品能否获得许可、列入药品报销目录、获得医疗保险报销的重要因素。
欢迎下载手册,了解如何快速高效地完成对照药采购策略和后续临床供应链分发的工作。

白皮书
5000L 一次性生物反应器:新一代生物制剂生产技术
随着全球生物制剂市场规模的持续扩大,生物制药领域的科学突破不断涌现,治疗药物的需求缺口和生物制剂适应症也在不断增加,生物仿制药也越来越多。

资料页
Quadrant 2™:可提高溶解度和生物利用度的预测平台
Quadrant 2® 是用于药物早期开发的诊断工具,可使用计算机对制剂进行预测。这项工具提供的预测结果可以避免试错,让我们能够迅速提供增溶解决方案,从而节省时间和成本。

资料页
Quadrant2®—提高难溶性药物溶解度和生物利用度的创新方法
欢迎下载资料,了解赛默飞Patheon™ 制药服务事业部自主开发的 Quadrant 2® 平台通过计算机建模,来帮助客户预测难溶性化合物增溶的可性性和策略, 包括增溶技术及辅料工艺的选择。通过 Quadrant 2® 能够帮助客户最大限度减少处方前和早期临床开发项目的实验工作量。

资料页
高活性药物从早期开发到商业化生产的控制策略
本次演讲将介绍高活化合物毒性分类系统及暴露等级,以及相应控制手段。欢迎下载资料,详细了解赛默飞Patheon™ 制药服务如何通过风险评估确认小分子化学药在开发阶段和商业化的过程中不同阶段高活化合物的控制手段和策略。

信息图

手册
冷链物流解决方案 : 实时跟踪与追溯数字平台
实时跟踪与追溯平台使我们的专家团队能够在药物运输途中降低或避免温度偏差。该平台信息的透明可视化为我们的客户和临床试验参与者提供了他们所需的保证,即药物在规定条件下准时分发到指定的地点。

线上讲座
出海成势:大分子药物CMC环节要素解析
为了深入探讨大分子药物出海策略,以“出海成势,大分子药物CMC环节要素解析”为主题,赛默飞Patheon™生物制药和无菌灌装服务全球技术专家胡可可老师与百奥泰生物制药股份有限公司高级副总裁刘翠华博士将讨论在新环境、新形势下,思考如何通过CMC环节助力中国大分子药物“出海”。

客户案例

白皮书
已有药物再利用趋势与缩短药物开发周期的战略方法
从CDMO合作伙伴的角度,概述低风险、具有成本效益的药物再利用策略的趋势,以将非专利仿制药、临床、暂时搁置药物或联合用药用于治疗不同的适应症并加快上市速度。

线上讲座
共研国内创新药企的出海之路—新环境下的MRCT
本次直播分享围绕 MRCT 法规策略,就如何开展 MRCT,在过程中又将如何优化药品供应加速临床试验进度等几个方面展开探讨,介绍 MRCT 中常见的挑战、策略、实际案例及相关的解决方案。

资料页
大分子药物如何从立项开始规划符合 全球法规监管的CMC策略
如何制定国际化的研发路线,才能脱颖而出、成功出海?
欢迎下载讲座资料,了解如何从立项开始规划符合全球法规监管的CMC策略,满足药物CMC的科学与合规“双轨制”满足国际化要求。

信息图

信息图
小型生物技术企业 CDMO 合作策略路径图
作为创新生物技术企业的顾问,下载该路径图了解何种 CDMO 合作伙伴可以带领您的生物技术客户走上理想的道路,并准时完成客户的项目,进而确保监管流程和市场推广的顺利进行。

资料页

信息图
实用指南:编写完善的CMC资料,为首次人体临床试验提供支持
您是否需要整理您的首次人体试验(FIH) 文书工作?
为药品注册通用技术文件 (CTD) 起草信息丰富、适应不同阶段需求的药学(CMC) 资料,使您的首次人体临床试验 (FIH) 的文书工作有序进行。

专家

专家

专家
Jennifer A Head, PhD
Manager of Regulatory Affairs, Microbial Manufacturing Services (MMS)
专注的领域
生物制品(大分子原料药)

专家

专家

专家

专家
线上讲座
技术转移加速中和抗体工艺开发和商业化进程—成功策略与案例分享
欢迎观看由赛默飞Patheon™ 制药服务事业部生物制药战略及产品高级总监姜灿平博士带来的线上讲座“技术转移加速中和抗体工艺开发和商业化进程—成功策略与案例分享”

白皮书
从 CMC 角度阐述如何加速生物制剂 BLA 申报
随着疫情的常态化,更多项目数据将支持监管机构进行科学评估,以进一步催生生物工艺开发的变革,生物药的研发周期也有望进一步压缩。本白皮书将简要从 CMC 角度阐述如何加速生物制剂 BLA 的申报策略。

资料页

线上讲座
抗体类药物无菌注射剂开发过程中选择预充式注射器的挑战和策略
赛默飞全球SME王新峰老师将在本次讲座中分享预充针注射器市场趋势以及优势,并一同探讨注射剂开发生命周期过程中,当从西林瓶转化为预充式注射器时,如何对项目进行科学计划安排,识别潜在风险,并采用合理的应对措施,确保转换过程中不会造成注射剂产品整体的质量影响。

资料页
抗体类药物无菌注射剂开发过程中选择预充式注射器递送形式的挑战和实施策略
欢迎下载讲座资料,了解预充式注射器的优势,如何准备进行预充式注射剂的设计和从西林瓶向预充式注射器转换过程中需要注意的要素。

线上讲座
为生物制药商业化做好准备:风险降低和结果优化策略
药物开发过程中往往存在风险和机遇,这就要求制药企业既要选择正确的后期策略来加快进度和优化产能,同时还要保持足够的灵活性以适应不断变化的市场形势,这对致力于生物制药产品开发和商业化的公司构成了重大挑战。

线上讲座
加速技术转移,融化资本寒冬
欢迎观看由赛默飞 Patheon™ 制药服务澳洲工厂生物工艺总监 Evan E Shave 博士和信达生物MST负责人袁冶博士举行的线上演讲,了解我们是如何整合内外部资源加速技术转移,推进管线冲刺。

线上讲座
海外寻路,解锁创新药物的海外上市密码
近几年来,国内创新药出海逐步增多,但要做到出海成功仍需面临多重挑战。欢迎观看本次创新药出海秘籍线上讲座,聆听行业专家大咖对于创新药快速切入海外市场的策略和建议。

线上讲座
赛默飞30年经验加速抗体药物——工艺开发和商业化的策略及实战分享
欢迎观看由赛默飞Patheon™ 制药服务事业部全球 SME 王新峰带来的线上讲座“赛默飞 30 年经验加速抗体药物——工艺开发和商业化的战略及实战分享”。

客户案例
灵活性使自动包装线管理大尺寸产品说明书变为可能
某大型跨国制药公司要求赛默飞费伦蒂诺工厂解决因需要加大产品说明书的尺寸而随之出现的问题。这些说明书对于满足法规监管和营销需求非常重要。下载了解更多

白皮书
生物制药工艺过程的工艺表征和验证中必须了解的相关知识
由于单克隆抗体的普遍性,整个行业形成了强大的知识体系,可用于缓解生物药管理生命周期中的重大风险。其中包括生物药物分子商业化所需的工艺表征和验证的重要步骤,其中的过程控制策略可帮助最大限度减少风险并控制质量。

手册
赛默飞 Patheon™ 制药服务概览
赛默飞Patheon™ 制药服务为药物开发和临床试验提供一体化端到端解决方案,本概览手册将助您了解我们丰富的经验和专业的知识,及行业领先的一站式 CDMO 服务及临床供应链服务,帮助您成功完成药物开发。

白皮书
生物原液药开发过程中的 CMC 策略
近年来,随着我国生物制药自主创新能力的提高,在药物成本、质量控制及合规性方面,药物的药学研究显得愈发重要。中国加入ICH后,更是推动了药物研发与全球标准的接轨。 本文将结合当前国内外法规趋势,及药企在开发过程中出现的药学共性问题,对原液生产过程中的相关关注点和基本考虑进行总结。

白皮书
小型生物制药公司面临的五大风险
对于生物制药公司而言,不仅药物开发始终充满风险,而且还面临着开发时间紧迫和预算有限的问题。它们经常会忽视一些关键因素,这可能会导致接下来的工作推迟或被搁置。顾问应帮助客户了解五大风险,以免在开发过程中出现解决成本高昂的问题,并最大程度地提高经济回报。

白皮书
肿瘤药物开发格局日新月异:创新疗法拯救患者的生命
现今的制药肿瘤学发展格局与十年前相比已经大不相同。作为药物开发领域发展最快、最活跃的细分方面,科学与技术的突破性发展推动了肿瘤学的进步,科技的进步加深了研究人员对癌症生物学、免疫学和遗传学的研究。

白皮书

电子书
投资您的生物制药公司时:投资者可能会向您提出的常见的十个问题以及该如何应答
制定新药计划需要解决许多值得重点考虑的问题。而毫无疑问,其中最大的困难之一是如何获得实现下一个里程碑所需的资金。在您因为资金问题而焦头烂额时,考虑潜在投资者的态度可能会有所帮助。投资者希望您能有效管理开发并加速开发。

电子书
您可能会面临严厉的监管环境:了解药物开发的七大新风险
您需要考虑技术转移、运输和物流等问题以及各国日益复杂的法规监管要求。大型制药公司往往具备充足的人员和经验来进行药品和辅材的境内和跨境管理和运输,但新兴制药公司大多采用精益经营模式,侧重于科研。因此,您可能不具备资源或专业人员来协调涉及多家工厂、多个地区或多个供应商的开发项目。本电子书旨在帮助您了解药物开发和临床服务的七大风险并制定相应的风险规避计划。

电子书

线上讲座
细胞和基因治疗产品商业化的灵活法规途径和关键 CMC 考量因素
推动生物制品进入首次人体试验(FIH)首先需要对这些复杂大分子所面临的科学和法规监管挑战的深入了解。从最早期阶段到整个临床开发过程中,需要优先考虑 CMC 指导并精心准备高质量的文件包。

线上讲座
加速生物制品开发进程:从实验室到临床试验和商业化阶段
欢迎观看在线讲座,了解赛默飞如何支持新兴生物科技公司加速从临床到商业化的过程。CDMO 合作伙伴不仅是服务的提供者,更是药物生产供应链的重要部分。CDMO 和客户的紧密合作是药物开发和商业化成功的重要基础。

线上讲座
口服固体制剂开发与生产的风险评估策略
无论是在药物开发中的哪个阶段,如果您想要实现工艺放大,都需要关注很多细节问题。从早期开发到商业化生产,您都需要制定前瞻性的策略,以规划 API 和药物制剂变化的潜在影响。

线上讲座
去中心化临床试验在不断变化的欧盟监管形势下的前景
新冠疫情大流行证明临床试验从传统的有实体场所试验模式转变为完全去中心化或部分去中心化试验模式是可行的,去中心化临床试验作为安全有效的临床研究加速方案在全球范围内越来越受到青睐。

线上讲座
如何利用灵活应变的生产模式稳步迈向充满不确定性的未来
在短短 20 分钟内,您将会了解到制药行业的趋势和灵活应变的生产模式,并参观 Pacira 公司在 Patheon 英国斯温顿工厂的共管生产设施。

手册
领先的细胞和基因治疗病毒载体 CDMO 服务
Patheon 拥有 14 年以上的病毒载体服务经验,作为您的端到端病毒载体 CDMO 合作伙伴,从工艺和分析方法开发到临床和商业化供应的各个阶段,都能为您的细胞和基因治疗产品以及疫苗提供病毒载体。

手册
为各类临床试验提供全球临床供应解决方案,按时、保质、保量地将药物交付至所需的患者手中
在竞争激烈的新药开发市场中,生物制药公司面临着各种挑战,包括平衡成本、时间和质量以及为临床试验和患者提供最佳结果。

资料页
无菌制剂的全球投资与创新技术
我们帮助客户开发并交付的药物每天可以改善 100 万名患者的生活。随着客户与市场对我们服务、专业知识和能力的需求不断增加,我们承诺持续扩大产品和服务范围。因此,我们以前所未有的投资力度扩张全球工厂和能力网络。进一步了解赛默飞在北美、亚太地区和欧洲进行的无菌制剂投资。

客户案例
原料药 CDMO 选择的重要性:客户见解
小型新兴生物技术公司因资金和资源(例如技术水平和产能)有限而面临巨大挑战,必须找到实力强劲的合作伙伴来提供支持。了解 4SC 公司为何选择赛默飞制药服务作为其 CDMO 合作伙伴,合作开发其主打产品 Resminostat。

客户案例
临床辅材管理——攻克全球化糖尿病治疗药物临床试验的难题
某大型药企的全球化糖尿病治疗药物临床试验需要支持。一项临床试验通常招募 1,500 至 2,000 名患者,这些患者来自美国、欧盟、亚洲和中东的 15 至 20 个国家/地区。

信息图
CDMO“避雷”指南:五个方面说明 CDMO 选择失误会如何阻碍项目的成功
在不断变化的生物制药行业中,唯一不变的就是:药物开发充满着不可预测性。当科研人员希望平衡好纯度、活性、安全性和稳定性时,从细胞株到商业化阶段,大分子药物自然会产生复杂的生物活性。

信息图
小药企,大机遇:为大分子药物项目选择 CDMO 合作伙伴时,是否应考虑 CDMO 的规模?
概述:在无菌制剂的早期开发过程中,由于资源有限和工艺开发方面的挑战,新兴生物技术公司经常难以决定选择小型还是大型 CDMO 作为其合作伙伴。这项关键决定不仅会影响早期开发,还会影响工艺放大和商业化。

信息图
两家CDMO的故事:您的生物制药公司将作出何种选择?
如今生物制药面临的挑战不断增多,选择什么样的 CDMO 显得至关重要。从 DNA 序列到药物商业化销售,整个过程中的每一个环节,您都需要一个值得信赖且经验丰富的合作伙伴。

博客
关于如何管理临床标签翻译和监管要求的重要提示
通过一种方法顺利应对临床试验涉及到的各个国家/地区的标签翻译和监管要求岂不更好?最让人沮丧的事情莫过于既要试图弄清监管要求、制定相应的合规文本,同时还要兼顾处理与临床试验规划相关的所有其他日常活动。提前进行一些规划有...
阅读时间:2分钟

博客
为特殊药品扩展包装服务
成功开发治疗复杂疾病或罕见疾病的特殊药品的确可喜可贺。然而,很多制药企业随后都会面临另一项挑战,即:在新药上市后,确保向患者持续供应小批量药品...
阅读时间:2分钟

博客
选择真正精通生物制药的 CDMO
随着生物制剂生产行业中 CDMO 数量的增加,新兴生物制药公司难以抉择合适的 CDMO。选择 CDMO 是一项艰巨任务,关键是要找到一个合作伙伴能够无缝处理生物制剂生产的各方面,从加速药物上市到降低风险,再到给予分子药物必要的关
阅读时间:8分钟

博客
应对工艺性能确认的复杂性
在工艺性能确认 (PPQ) 之前进行方法确认非常重要。在早期阶段对您选择的方法进行性能特征评估至关重要,因为这涉及到方法验证及其参数,如精密度、准确度和线性度等。最重要的是,这些分析考虑因素不仅能够证明药物的质量和安全性...
阅读时间:5分钟

博客
提升您原料药 (API) 的开发水平:外包前需要考虑的三个步骤
随着原料药开发外包的普及,多个医药合同定制研发生产企业 (CDMO) 作为潜在开发合作伙伴展开激烈竞争的现象越来越常见。在这种形势下,小型/线上生物技术公司能够以远低于在工厂中建造、租赁或购买实验室场地的成本将药物从概念阶...
阅读时间:10分钟

博客
突破对非处方药 (OTC) 的限制
非处方药品 (OTC) 的消费者往往选择在实体药店或线上零售药店里购买,方便他们选择各种各样的非处方药从片剂和胶囊到糖浆剂,消费者可以选择的 OTC 剂型比以往更多。如果要在竞争激烈的行业中突破对非处方药 (OTC) 的限制或脱颖而出...
阅读时间:8分钟

博客
影响罕用药开发的因素和障碍
根据美国食品药品监督管理局 (FDA),“2020 年,提交给罕用药开发办公室的罕用药认定申请和罕见儿科疾病认定申请的数量创历史新高。”仅在美国就有 2,500 多万名罕见病患者,罕见病是指患者数量少于 20 万人的疾病。据估计目前全球...
阅读时间:6分钟

博客
简化您的 API 开发流程
新药开发的主要方式日新月异。在过去,制药公司(尤其是大型的制药公司)都是在内部开发原料药 (API)。这种 API 开发模型的目标是完成 API 从发现到开发的流程,最终将新药推向市场。通常这种策略需要自筹资金,由制...
阅读时间:7分钟

博客
连续生产:高效生产口服固体制剂 (OSD)
当 1913 年亨利·福特 (Henry Ford) 在美国密歇根州海兰帕克革新生产实践时,他的主要目标很简单——以最高效且最具成本效益的方式生产出最好的产品。福特专注于改善生产“流程”,让工人/技术更智能地发挥作用,减少原料浪费,这一举措...
阅读时间:6分钟

博客
病毒载体合作伙伴的日常
病毒载体医药合同定制研发生产企业 (CDMO) 应具备哪些素质?人们期望 CDMO 拥有科技知识和监管专业知识,从而应对快速发展和不断变化的病毒载体行业。但 CDMO 应该如何处理与其他制药公司之间的合作关系呢?...
阅读时间:9分钟

博客
在新冠疫情 (COVID-19) 期间,去中心化临床试验如何更好地强化“以患者为中心”的服务理念?
随着新冠疫情对生物制药行业发展模式的不断改变,对于我们而言,目前最重要的是保持初心:挽救患者生命并改善其生活质量。我们与患者互动的方式在不断发生变化,临床试验等很多研发工作的开展也不再依赖于传统的面对面互动方式。无论...
阅读时间:5分钟

博客
高效工作,不做无用功:加速生物制剂的开发和商业化
在过去的十年中,生物制剂行业实现了两位数的增长,扩大了总体市场份额。事实上 根据 2020 年市场预测报告,到 2026 年,全球生物制剂市场规模预计将达到约 1,500 亿美元...
阅读时间:5分钟

博客
遵循细胞和基因治疗法规:您的 CDMO 是否合适?
许多大型或新兴生物技术公司内部缺乏资源和/或专业知识无法很好地为注册申报提供适当支持。大型和小型制药公司都必须及时、持续地为患者提供改变生活的药物,同时又要遵守重要的监管指南,确保药物安全、纯净且有效...
阅读时间:7分钟

博客
设备确认的四个阶段
如我之前的博客所述,确认是指汇编书面证据证明特定设备、设施或系统正确安装,正确运行并得到预期结果的过程。该过程证明生物样本库中的设备能够在设定的范围和公差范围内持续运行,该过程还能测试工艺中的元件或组件,以验证特定结果...
阅读时间:3分钟

电子书
抗体蛋白类药物稳健冻干工艺的开发和放大策略
制备固体蛋白药物最常用的方法是冻干制剂,可以有效提高稳定性,方便保存、运输,降低成本和潜在病人使用风险。本电子书将探讨抗体蛋白类冻干制剂的开发挑战、方式、注意事项和未来展望。
















































































































